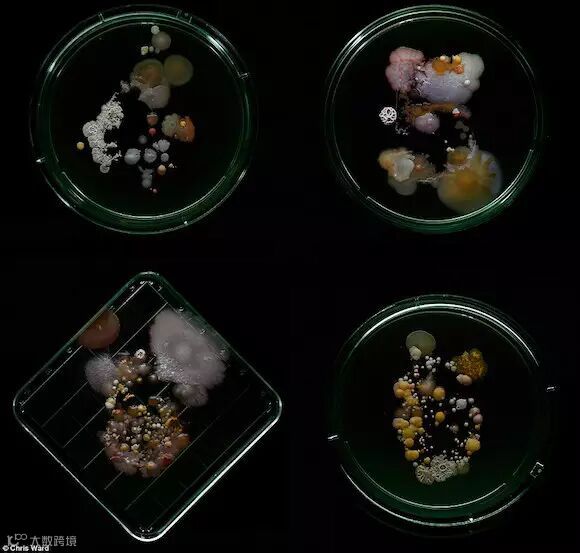
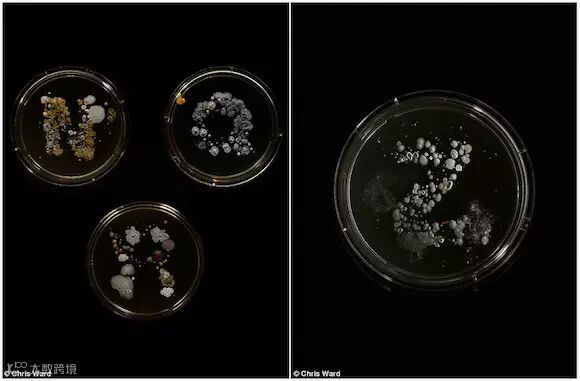
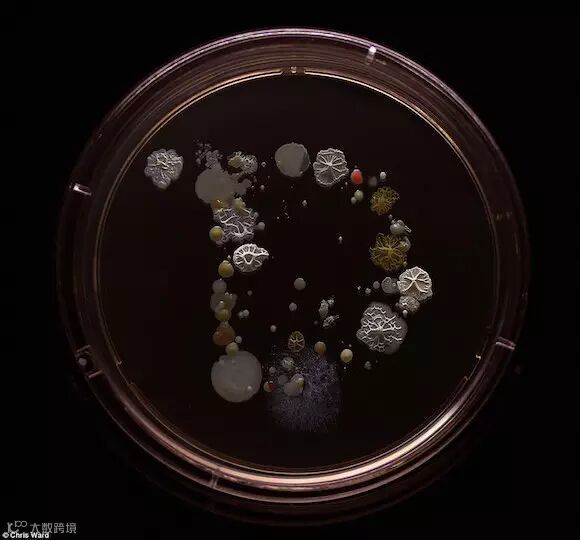
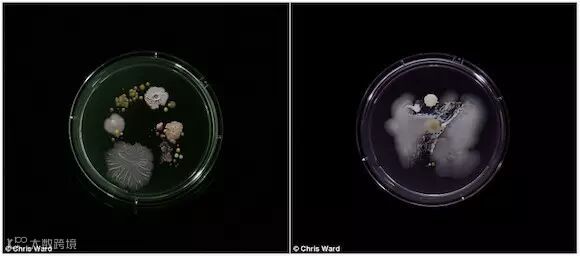

来这里找志同道合的小伙伴!
来这里找志同道合的小伙伴! 这个艺术家想要告诉我们,在每天的地铁时间里,我们的双手沾上了多少细菌。
这个艺术家想要告诉我们,在每天的地铁时间里,我们的双手沾上了多少细菌。
午夜降临,你独自坐上了末班的地铁。

你以为你是一个人,然而并不是。
碰到扶手的那一霎那,你几乎同时和上百人握住了手。
他们还毫不吝啬地给了你来自陌生人的馈赠。

它们像金属一样闪闪发亮,五彩斑斓,美好得就像精心设计的那样。
它们有一个共同的名字,叫做细菌。
Craig Ward,来自美国纽约布鲁克林区的插画家兼艺术家,在他的“看不见的地铁”里,让科学遇见了艺术。
在纽约地铁上读到微生物学家Tasha Sturm关于细菌的一个项目时,Craig Ward想起了那个古老的都市传说:
抓住地铁扶手相当于同时在和一百个人握手。

你大概从此再也不想和地铁扶手产生任何肢体接触,但Ward却为这其中的浪漫联系深深着迷:
小小的一节车厢里,装着看得见的我们,和看不见的无数细菌。
我们短暂相遇再擦肩而过,什么都没有留下,除了它们。
从纽约地铁的L线开始,Ward用无菌海绵收集扶手上的细菌,

随后便在培养皿里,发现了来自陌生人的礼物。
来自L线的细菌,后来成为他最喜欢的一批。
它们形状繁复,色彩华丽。

右图为L线上的细菌,其中包括奇异变形杆菌、滕黄微球菌、枯草杆菌和粘质沙雷氏菌。
在这些黄色、粉色和白色的微生物里,Ward还在科罗拉多州一个细菌学家的帮助下发现了大量的传染物,如大肠杆菌、沙门氏菌和葡萄球菌。

……
不管你愿不愿意,Ward认为,这些细菌和形形色色的纽约客一起构成了纽约。
“你看向地铁,里面有着不同块头和肤色的人;在微观层面看的话,布满的却是不同颜色形状和大小的细菌种群。”他说。
纽约地铁一直很忙……
不过最近有一项研究发现,它们可能比我们想象的还要挤得多。
2015年2月,维尔康奈尔医学院的科学家们在 Cell.com发表了一项最新研究成果。
在过去一年半的时间里,他们仔仔细细地研究了地铁的刷卡机、售票亭、栏杆和长椅,发现有15152种微生物每天和550万名乘客一起坐地铁。
右图为7号线上的细菌,包括金黄色酿脓葡萄球菌和滕黄微球菌。
他们公布了一份纽约地铁微生物和DNA地图,从上面可以看出哪些地铁站是细菌重灾区。
这项研究自2013年开始,研究人员共发现了637种已知的细菌、病毒和真菌。
大部分菌群是无害的,虽然有48%的DNA无法和任何已知的生物物种匹配。


在466个开放的车站中,近一半都发现了与食物中毒等疾病相关的细菌。

不过专家们也说了,其实太危险的细菌并不多见。
他们只在三个车站找到了和痢疾以及鼠疫有关的细菌,而且还是死的。

他们还说,大多数有害菌群数量较少,有益或中性菌群在数量上是占优势的。
而且人体的免疫系统也能够抵御这些扑面而来的微生物。
不过首席研究员Chris Mason博士还说了,也别没事就舔舔扶手了……
Chris Masonh还建议把孩子暴露在细菌环境中,以此提高他们的免疫力。
“对于新生儿童,最好就是把他们像寿司一样在地铁里滚上一圈。”他说。

来源:Daily Mail 整理:100allin环球运费网
原标题:The bacteria sharing YOUR subway carriage: Artist grows germs collected from every line in New York Read more: http://www.dailymail.co.uk/sciencetech/article-3342027/What-REALLY-lives-New-York-subway-Artist-documents-terrifying-spread-bacteria。
· · · · · · · · · · · · · · · · · · · · · · · · · · · · · · · · · · · · · · · · · · · · · · · · · · · · · · · · · · ·
额额额额额额额额~~~~~完结了。
看完之后是不是很想揍那位艺术家,告诉了我们如此残忍的现实。总之,重口味的文章看完了,是不是该去厕所洗洗手了?


